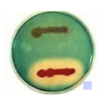

Stereotyping:
Use of antibodies to detect specific pathogens located on cell surface
Molecular biology is based on:
Based on genotype and nuclei acid sequences
MALDI - TOF MS based on:
Characterization of microbial proteins
Lactose utilization:
Most important carb determination
Can be used to differentiate lactose fermenting vs. Non-lactose fermenters
Lactose is:
Glucose and galactose
Lactose degradation:
Requires b-galacto side permease (transports lactose through cell wall) and b-galactosidase ( breaks lactose to yield subunits). Afterwards, glucose is available for metabolism
Some bacteria lack permease, but still have
B-galactosidase
Two pathways of glucose metabolism are
Embolden - myerhof-parnas pathway and entner-dovdoroft pathway
Fermentation:
Anaerobically utilized. Glucose to pyruvate that’s oxidized to other acid products and gases
Acid detected by pH indicates. Single acid and double/mixed fermenters.
No oxygen, uses a different inorganic molecule
Oxidation:
Aerobic, glucose to pyruvate to CO2
Generally weak acid producers, acid neutralized by alkaline reaction from peptones
O/F Basal Media (OFBM) Purpose and Description:
Help classify as oxidizer or fermenter, lower concentration of peptones
- pH indicator is bromothymol blue.
- Uninoculated is green.
- Acid pH is yellow.
- Alkaline pH is blue
Triple Sugar Iron Agar (TSI):
- Contains sucrose, glucose, and lactose
– Lactose and sucrose present in 10:1 ratio to glucose.
– Kligler iron agar (KIA) is similar but no sucrose. - Ferrous sulfate and sodium thiosulfate
– Detect production of hydrogen sulfide (H2S), which gives a black color - Phenol red
– pH indicator - Below 6.8 yellow (acidic)
- Above 6.8 red (alkaline)
- Reaction chambers
– Slant is aerobic.
– Butt is anaerobic
Reactions on TSI or KIA:
must be read at 18 and 24 hours
read as slant/butt
Ortho-Nitrophenyl-β-D-
Galactopyranoside (ONPG) Test Purpose:
To determine if an organism is a dLF (one that lacks the enzyme β-galactoside permease but possesses β-galactosidase) or is a true NLF
ONPG test mechanism:
- ONPG is structurally similar to lactose, but ONPG is
more readily transported through the bacterial
plasma membrane - β-Galactosidase hydrolyzes ONPG, a colorless
compound, into galactose and o-nitrophenol, a
yellow compound. ONPG remains colorless if the
organism is a NLF and becomes yellow for a dLF
Steps to perform ONPG Test:
– Make a heavy suspension of bacteria in sterile saline
– Add ONPG disk/tablet.
– Incubate at 35° C.
– Positive results usually seen within 6 hours
Glucose metabolism:
Occurs via the Embden–Meyerhof pathway, produces several intermediate by-products (pyruvic acid which can then degrade into mixed acids as end products)
Enterics take two separate pathways:
mixed acid fermentation and butylene glycol pathway
The methyl red (MR) and Voges–Proskauer (VP) test
detect
end products of glucose fermentation
MRVP Test Procedure Highlights:
- Inoculate glucose-containing broth.
- Incubate for 3 to 5 days.
- Transfer half of bacterial suspension into a
clean dry tube for the VP test. - Remaining half of suspension is for MR test
Decarboxylase test:
Test the presence of enzymes capable of removing carboxyl group (COOH)
- Specific for amino acids like lysine, ornithine, arginine
Lysine - lysine decarboxylase - cadaverine + CO2
Ornithine - Ornithine decarboxylase - putrescine + CO
Dihydrolase test:
Arginine - arginine dihydrolase - citrulline - ornithine
- putrescine
Moeller Decarboxylase Base Medium Description:
Broth medium used to detect decarboxylation (contains glucose, peptones), pH indicators are bromocresol purple and cresol red
– Specific amino acid at a concentration of 1%
– Overlay with oil
– Initial pH of 6.0
Uninoculated is purple; initial fermentation drops pH to 5.5: turns medium yellow
Deaminase Test Description and Procedure:
Amino acids can be metabolized by deaminases that remove an amine (NH2) group